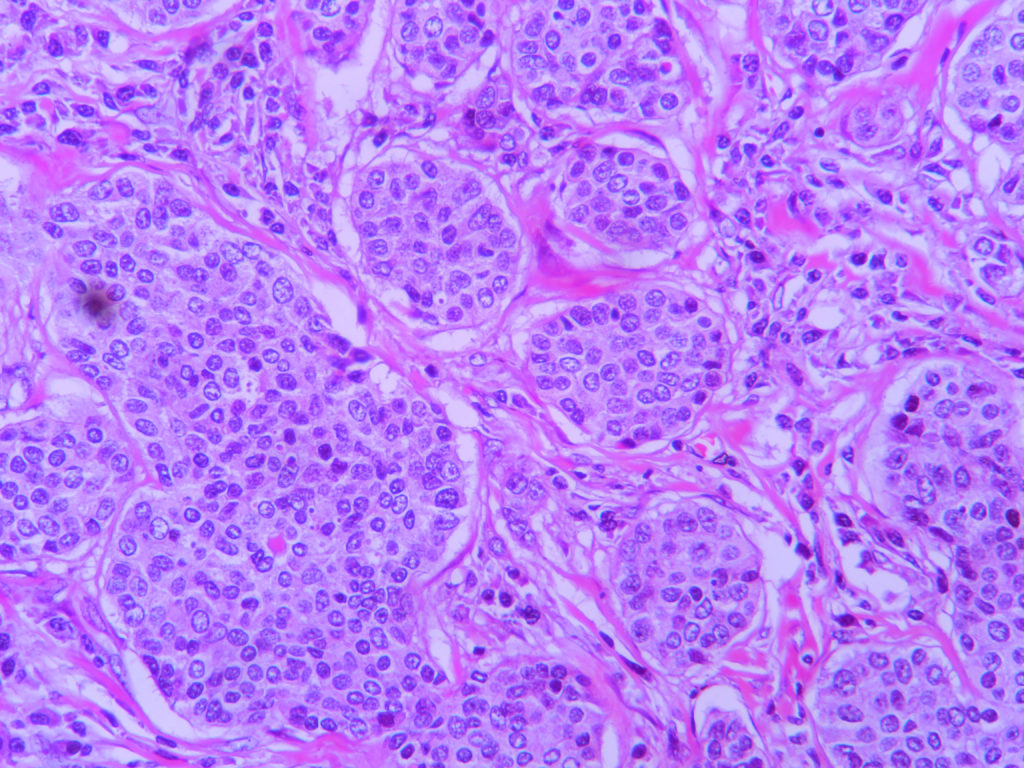

Salivary Gland Carcinoma, NOS (Adenocarcinoma, NOS)
Adenocarcinoma not otherwise specified
Adenocarcinoma not otherwise specified (AdCaNOS) is a rare salivary gland cancer that lacks defining features and does not fit the criteria for other known types of salivary gland cancer (1).
AdCaNOS affects more men than women and most patients are diagnosed in their late 50s (2, 3). AdCaNOS normally form as a solid painless lump in the parotid gland or in the minor salivary glands (4). The parotid gland (just below and in front of each ear) is one of the three major salivary glands, which are responsible for producing approximately 95% of saliva (5). Minor salivary glands produce the remaining saliva and can be found in almost any part of the mouth (5). Most cases of AdCaNOS that occur in the minor salivary glands, form in the roof of the mouth, otherwise known as the palate (4).
Experts can diagnose AdCaNOS by looking at cells under a microscope and ruling out more common salivary gland cancers (3, 4). AdCaNOS is an aggressive tumour, that can spread to other parts of the body (3). Tumours in the mouth have a better long-term outlook than those found in the submandibular gland (below the jaws) or parotid gland (3). The main treatment is surgery to remove the entire cancer, and in some cases, this is followed by radiotherapy and chemotherapy (4).
Useful resources
Read more about how to get your tumour profiled and add to the research biobank at the Christie Hospital in Manchester, UK here:
- Gene profiling or tumour profiling or genomic testing - Salivary Gland Cancer UK
- Donate tissue to the Biobank - Salivary Gland Cancer UK
References
1. Skálová A, Hyrcza MD, Leivo I. Update from the 5th Edition of the World Health Organization Classification of Head and Neck Tumors: Salivary Glands. Head Neck Pathol. 2022;16(1):40-53.
2. El-Naggar AK, Chan JKC, Takata T, Grandis JR, Slootweg PJ. The fourth edition of the head and neck World Health Organization blue book: editors' perspectives. Hum Pathol. 2017;66:10-2.
3. Li J, Wang BY, Nelson M, Li L, Hu Y, Urken ML, Brandwein-Gensler M. Salivary adenocarcinoma, not otherwise specified: a collection of orphans. Arch Pathol Lab Med. 2004;128(12):1385-94.
4. Dos Santos JL, de Almeida Milani Altemani AM, Trivellato AE, Sverzut CE, Almeida LY, Teixeira LR, et al. Intraoral Pigmented Low-Grade Adenocarcinoma, Not Otherwise Specified: Case Report and Immunohistochemical Study. Head Neck Pathol. 2018;12(4):610-8.
5. Ghannam MG, Singh P. Anatomy, Head and Neck, Salivary Glands. [Updated 2023 May 29]. In: StatPearls [Internet]. Treasure Island (FL): StatPearls Publishing; 2024 Jan-. Available from: https://www.ncbi.nlm.nih.gov/books/NBK538325/.
Last updated April 2024